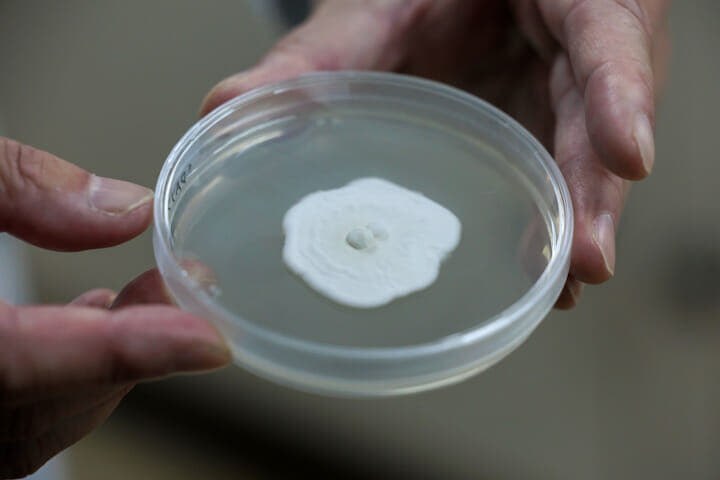
ナガセヴィータの藤崎研究所 トレハロースの研究

しかし、根粒菌製剤は長持ちせず保管時に課題がある。トレハロースには根粒菌の品質保持期間を延ばす効果があり、現地ですでに根粒菌に添付する試みがされていたのだ。
東山さんは「トレハロースの農業分野での活用に大きなポテンシャルを感じました」と当時を振り返る。一方で、現地での経験により持続可能な農業の必要性についても考えさせられたという。
「ブラジルを車で走っていると、ひたすら数時間、大豆農場の風景が続きます。そんな広大な畑に散布される化学農薬・肥料は膨大な量になり、コストやエネルギーも相当なもの。地球環境にとって『このままではいけない』と痛感し、自然に優しい農業のやり方へ変えていく必要性があると強く思いました。同時に、自然由来のトレハロースが問題解決に貢献できると考えました」
トレハロースに植物の免疫力を高めるBS効果
いま、自然負荷を考慮し、農薬・肥料は「化学からバイオへ」の切り替えが世界的な流れとしてある。バイオ農薬・肥料はヨーロッパを中心に普及し始め、一部の国・地域では法整備も進んでいる。
そうした中、ナガセヴィータは自社素材の農業用途拡大へ向け、独自調査を始めた。2023年にはブラジル・サンパウロ州立大学と共同研究を実施。同社によれば、インゲン豆を対象にした実験で、植物の生育を促しストレスを緩和する「バイオスティミュラント(BS)」の効果がトレハロースに認められた。
次のページ














